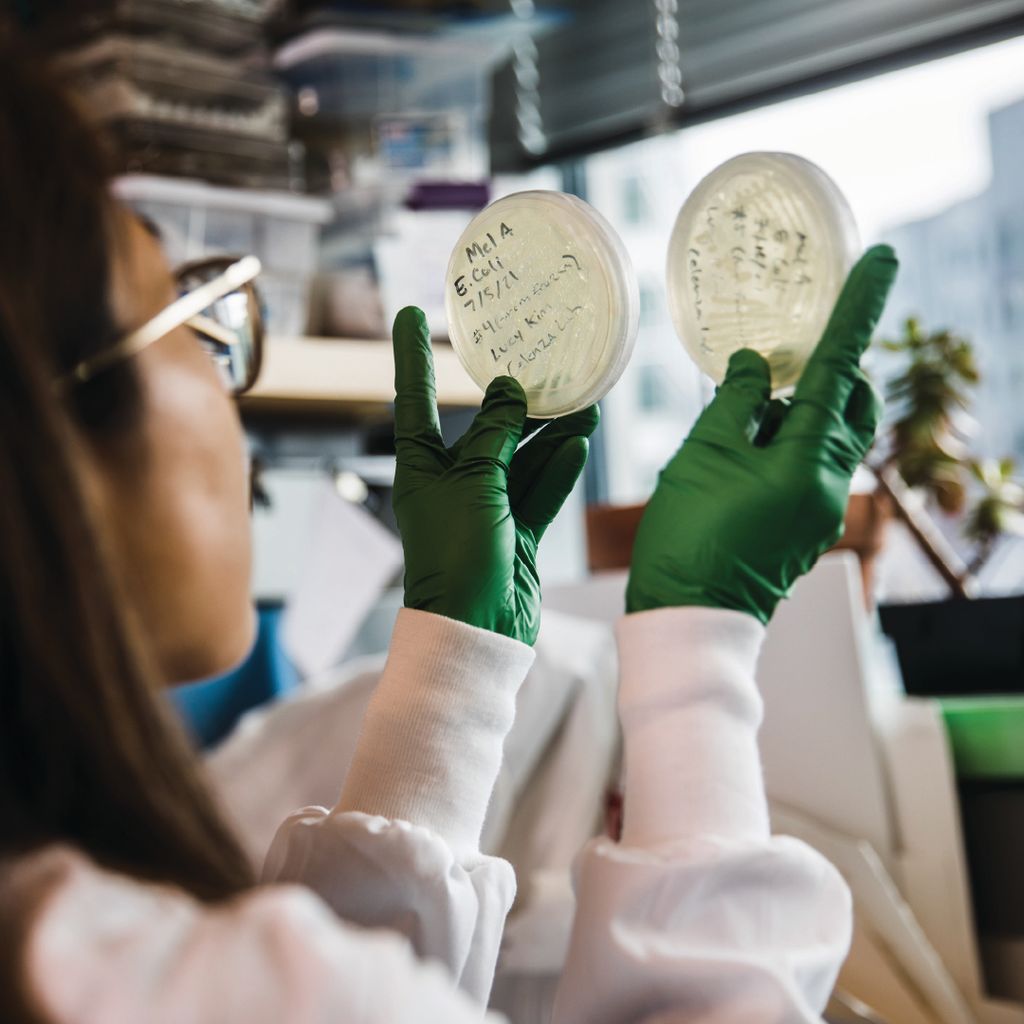

Interdisciplinary Art
More Like This
From Studio to Lab
Lucy Kim uses science to turn simple screen prints into organic creations.
Award-winning visual artist and CFA associate professor Lucy Kim has made a career of manipulating materials into paintings, sculptures, or hybrids that can’t be easily categorized.
Now she’s experimenting with a new material that shapes our lives in myriad ways: melanin. Kim is creating art with the natural pigment that gives our eyes, hair, and skin their color, using it to make captivating monochromatic screen prints.

Art House is BU’s Homegrown Sitcom
A true collaboration brought laughter and a behind-the-scenes look at the making of an original live-action TV comedy pilot to Booth Theatre, co-produced by BU College of Fine Arts and College of Communication.
“We were looking for different means of expression in which our students could perform, collaborate, and travel their artistic journeys. We’re a natural fit.” – Susan Mickey, former BU School of Theatre Director




Exit the King, and Enter RANDOM ACTOR
A School of Theatre production and School of Visual Arts workshop collaboration sponsored by BU Digital Learning & Innovation brought interdisciplinary artist Paolo Scoppola to Boston to work with students on the groundbreaking software.
The Spring 2022 production Exit the King unveiled software created at BU for stage projections.




Francisco Alarcon Is Helping Engineers and Artists Communicate
BU’s first computational artist-in-residence bridges the divide between two fields